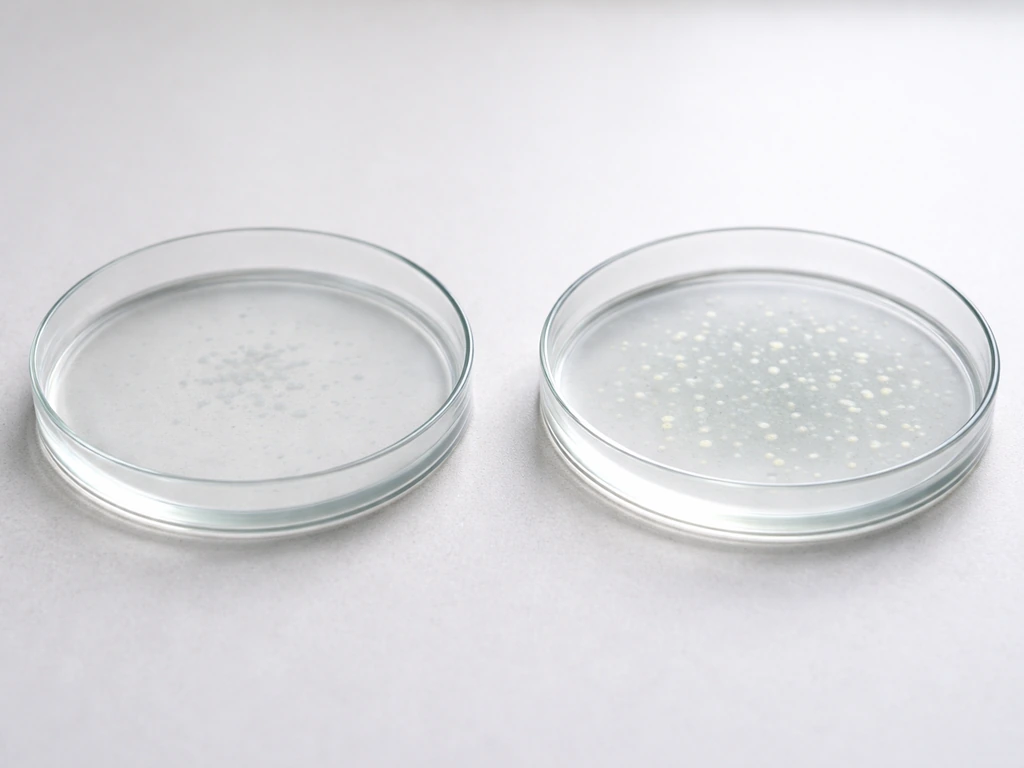
Minimal photo showing two simple groups of small bacteria-like dots: one shrinking, one increasing.

The short answer is: no, bacteria generally cannot grow and multiply in standard vinegar. Full-strength vinegar (at or above 4% acetic acid) creates a pH environment of roughly 2.4 to 3.4, which is acidic enough to halt the growth of virtually every common foodborne pathogen. But "can grow in vinegar" and "can survive in vinegar" are two very different things, and that distinction matters enormously for food safety decisions.
Can Bacteria Grow in Vinegar? pH, Survival, and Safety Tips
What vinegar actually does to bacteria
Vinegar's power against bacteria comes from acetic acid, specifically the undissociated (uncharged) form of the molecule. At low pH, a larger fraction of the acetic acid stays in its undissociated form, which means it can diffuse directly through bacterial cell membranes. Once inside the cell, it releases a hydrogen ion, dropping the intracellular pH and disrupting normal enzyme function. That's the core mechanism behind why acetic acid at low pH is more toxic than acetate at neutral pH.
Most household white vinegar and apple cider vinegar sit at 5% acetic acid, which is above the FDA's minimum standard of 4% acetic acid (4 grams per 100 mL) for commercially labeled vinegar. At that concentration and the corresponding low pH, most bacteria simply cannot maintain internal conditions needed to replicate.
Survival vs. growth: the distinction that actually matters
Saying bacteria "can grow in vinegar" implies they can reproduce and increase in number. That's almost never happening in full-strength vinegar. But surviving is a different story. Some bacterial cells can remain viable in an acidic environment for a limited time without multiplying, especially under the right conditions of temperature and initial load.
Research on Salmonella Enteritidis shows a useful example: at sublethal undissociated acetic acid concentrations and pH values in the range of 5.5 to 6.0, survival can actually persist longer than you'd expect. At pH 5.5, some cells manage to activate acid resistance mechanisms. But this is far above the pH of standard vinegar. In true full-strength vinegar (pH around 2.5 to 3), those survival windows close rapidly.
The practical takeaway: if a pathogen lands in pure, undiluted vinegar, it's being inactivated, not growing. Studies on E. coli and vinegar confirm that around 5–10% vinegar concentrations produce meaningful log reductions within about a day at refrigerated temperatures. That's reassuring for most real-world use cases, but it also tells you that vinegar is not instantaneously sterile the moment something drops in.
When bacteria can actually persist or multiply in vinegar
There are a handful of real scenarios where the normal rules break down. Understanding them is what makes the difference between informed food safety practice and false confidence.
Dilution is the biggest risk factor

When you dilute vinegar with water, you raise the pH. A 4% acetic acid vinegar diluted down to 1 or 2% might have a pH closer to 3.5 to 4.5, which is approaching a zone where some acid-tolerant organisms can start to function. Pickling brines, salad dressings, and marinades that use vinegar as only one ingredient often fall into this partial-acidity range. That's why pickle and acidified food recipes from trusted sources (like the USDA's canning guidelines) specify pH thresholds, not just "add some vinegar."
Nutrients and contamination
Plain vinegar has very little that bacteria can use for energy. But vinegar mixed with food, spices, herbs, or organic matter now has available nutrients. That combination, especially if pH has drifted upward due to dilution or ingredient buffering, can support limited microbial activity. A bottle of garlic-infused vinegar left at room temperature for weeks is a more complex microbiological environment than a bottle of plain white vinegar.
Biofilms and surface films

Some acetic acid bacteria, particularly Acetobacter species, can form pellicles or surface films at the air-liquid interface. Studies on static-fermented rice vinegar document film formation by Acetobacter pasteurianus even in high-acidity environments (above 8% acetic acid). These organisms produce polysaccharide matrices that help them withstand the very acid they generate. In a home or commercial vinegar setting, that translates to the floating film sometimes called "mother of vinegar," which is a biofilm of bacteria that convert alcohol to acetic acid when oxygen is present. It looks alarming, but in context, it's not a pathogen-related safety issue.
Which bacteria vinegar stops, and which ones are tougher
The list of pathogens that vinegar reliably inhibits at full strength is long and includes the ones most relevant to food safety. Here's a practical breakdown:
| Organism | Sensitivity to Vinegar | Notes |
|---|---|---|
| Salmonella spp. | High | Rapid inactivation at full vinegar pH; some short-term survival at pH 5.5–6.0 |
| E. coli O157:H7 | High | Meaningful log reductions within ~1 day in 5–10% vinegar at 4°C |
| Listeria monocytogenes | High | Generally inhibited at vinegar's low pH |
| Staphylococcus aureus | Moderate-High | Inhibited at standard vinegar pH; slightly more resistant than some Gram-negatives |
| Clostridium botulinum | High | Cannot grow below pH 4.6; vinegar-based pickling targets this threshold |
| Acetic acid bacteria (Acetobacter, Gluconobacter) | Very Low (acid-tolerant) | Thrive in vinegar; responsible for pellicle/mother formation |
| Lactic acid bacteria | Low-Moderate | More acid-tolerant than most pathogens; can persist in mildly acidic environments |
The key exception category is acetic acid bacteria themselves. These organisms evolved to live in acidic, high-acetic-acid environments and are not foodborne pathogens. Lactic acid bacteria are also notably more acid-tolerant than the pathogens you actually worry about, which is why fermented products like certain pickles involve lactic acid bacteria even in acidic conditions. For a deeper look at how acidity works in similar high-acid liquids, the breakdown of whether bacteria can grow in hot sauce covers many of the same pH and acetic-acid principles.
Cloudy vinegar, sediment, and knowing when to be concerned
This is where people tend to panic unnecessarily, or occasionally miss a real issue. Here's how to read what you're seeing.
"Mother of vinegar" (the floating gel or strand)

A gelatinous disc, strand, or cloudy mat floating in your vinegar is almost certainly mother of vinegar: a biofilm of acetic acid bacteria. Canadian food inspection guidance describes it exactly this way. It forms when oxygen reaches the surface of an alcohol-containing or partially fermented liquid. It's harmless in terms of pathogen risk, and many people simply filter it out and keep using the vinegar. It does not mean your vinegar is unsafe.
Sediment at the bottom
Sediment in unfiltered or raw vinegars (especially apple cider vinegar) is typically dead bacterial cells, proteins, and polysaccharides. It's not active growth. Apple cider vinegar's microbial properties are a common source of questions precisely because unfiltered versions look unusual. This sediment is cosmetic, not a safety signal.
When to actually be concerned
Be skeptical if the vinegar smells off (not sharp and acidic, but musty, rotten, or fermented in an unexpected way), if it has become significantly less sour over time (suggesting the acetic acid has been consumed), or if you've stored it diluted with food ingredients and it's been sitting unrefrigerated for an extended period. These are signs that pH may have shifted and the protective barrier has weakened.
Using vinegar for preservation: where it works and where it falls short
Vinegar is one of the oldest preservation tools available, and it genuinely works, within specific limits. The critical number to know is pH 4.6. Below that threshold, Clostridium botulinum cannot grow or produce toxin. Properly acidified pickles achieve this by getting the internal pH of the food (not just the brine) below 4.6.
This is why USDA home canning guidance and UConn Extension food safety resources both stress that acidified foods must actually reach the target pH, not just swim in vinegar. Thick vegetables can buffer the brine, slowing acid penetration. Cucumbers stuffed into a jar with diluted, low-acidity brine might not reach a safe pH throughout the food in the time you expect.
Vinegar also behaves differently from similar acidic liquids. Pickle juice's antimicrobial properties illustrate this well: the brine in commercially produced pickles is formulated to hit the right pH and often contains salt that adds water activity control on top of acidity. Home-made versions that approximate the brine without measuring pH can fall short.
For comparison, whether bacteria can grow in lemon juice comes up in similar preservation conversations, since citric acid also lowers pH effectively. The mechanism is similar, but acetic acid in vinegar tends to be more consistently inhibitory at equivalent pH because of its membrane-permeability behavior.
Best practices for vinegar-based preservation
- Use vinegar at 5% acetic acid (the standard commercial strength) for pickling, not homemade or diluted versions of unknown concentration.
- Follow tested recipes from USDA or NCHFP. These are calibrated for pH penetration, not just brine composition.
- Measure pH if you're adapting a recipe. Use a calibrated pH meter or strips accurate to 0.1 pH units. Target below 4.6 in the food itself, not just the brine.
- Don't reduce the vinegar ratio in a tested recipe to adjust flavor. This directly affects the pH achieved in the finished product.
- Refrigerate any vinegar-based preparation that isn't water-bath canned according to tested protocols.
Keeping your vinegar from becoming a microbial problem

Full-strength commercial vinegar is shelf-stable and self-preserving under normal storage conditions. But a few habits protect you in edge cases.
- Store vinegar in a sealed container. Oxygen exposure allows acetic acid bacteria to form surface biofilms, and prolonged exposure can eventually degrade quality.
- Keep vinegar out of direct sunlight and away from heat. While light and heat won't cause pathogen growth in full-strength vinegar, they can degrade quality and accelerate breakdown of complex vinegars.
- Never add water to a partially used bottle of vinegar to top it off. You're diluting it and potentially raising pH over time.
- For infused or herb-flavored vinegars, store them refrigerated and use within a few weeks. The added organic matter introduces nutrients that could support microbial activity if pH drifts.
- Don't double-dip utensils into a vinegar container that's used for both cooking and another purpose. Cross-contamination introduces organic material that can degrade the vinegar environment.
It's worth understanding that vinegar isn't uniquely different from other fermented or acidic condiments in terms of storage principles. How bacteria behave in soy sauce involves a similar concept: a harsh chemical environment (in soy sauce's case, salt and low water activity rather than acidity) that prevents pathogen growth but doesn't mean the product is immune to spoilage under poor storage conditions.
One comparison that sometimes surprises people: bacterial growth in dip powder is inhibited by low water activity (a dry environment) rather than pH. Vinegar relies on pH. These are two of the main preservation levers in food science, and understanding which lever a product uses helps you predict where it might fail.
The bottom line on bacteria and vinegar
Full-strength vinegar at 5% acetic acid is a genuinely hostile environment for the pathogens that cause foodborne illness. They don't grow in it. Some can survive briefly before being inactivated, but that window is measured in hours to a day, not weeks. The risk increases when vinegar is diluted, mixed with food, or stored improperly, because those conditions shift both pH and nutrient availability in ways that can allow acid-tolerant organisms to function.
For preservation purposes, vinegar works reliably when used at the right concentration, in tested recipes, with actual pH verification when you're adapting anything. Vinegar's acidity is powerful, but it's not a blanket guarantee of sterility, especially once you start diluting it or adding ingredients.
If you're seeing something unusual in your vinegar, like a floating film or cloudiness, in most cases you're looking at acetic acid bacteria or mother of vinegar, not a pathogen problem. The smell and taste test is your most practical quick check: good vinegar is sharp, sour, and clean-smelling. If it's not, something has gone wrong with the environment around it, not usually inside the vinegar itself.
FAQ
If bacteria cannot grow in vinegar, why do I sometimes see clouds or strings? Are they pathogens?
Bacteria can potentially remain alive for a short period in full-strength vinegar, but they do not multiply there in most home scenarios. If your goal is safety, treat vinegar as inhibitory rather than sterile, meaning any contamination should still be removed and the food or surface cleaned instead of relying on “soak in vinegar” as a kill step.
Does “mother of vinegar” mean my vinegar is unsafe?
Cloudiness or floating films are usually related to acetic acid bacteria (the “mother of vinegar”) rather than foodborne pathogens. Pathogens are typically stopped by vinegar’s low pH, while acetic acid bacteria can survive and form visible biofilms at the air-liquid interface. Still, if you made the vinegar part of a food storage process and it smells truly rotten or tastes unusually off, discard it.
How can I tell if my vinegar is strong enough to prevent bacterial growth?
Don’t assume any vinegar at home is automatically “strong enough” if it’s been diluted, leftover in recipes, or labeled differently. Check the label for percent acetic acid and, if you are using vinegar for preservation (like acidified pickles), verify pH with a reliable meter or test strips rated for the range involved, because small dilution changes can move you toward a safer or less safe zone.
Can bacteria survive longer in vinegar when vinegar is mixed with food?
Yes, bacteria can sometimes survive better in vinegar when the vinegar’s pH is higher than expected, such as in partially diluted mixtures or when ingredients buffer the acid. For example, marinades or dressings that include sugar, oil, or other components can reduce the effective acidity around the food surface, even if the overall jar still contains vinegar.
Why is it risky to make pickles or acidified foods without measuring pH?
If vinegar is diluted with water or used as a “quick pickle” with no measured pH, you can accidentally create a less hostile environment. A key failure mode is thick or layered foods that do not let acid penetrate quickly, so the center can remain at a higher pH than the brine. For anything preservation-related, follow a tested recipe and confirm pH for safety.
Does putting vinegar (or vinegar-soaked foods) in the refrigerator make it safe even if it was diluted?
Refrigeration mainly slows the overall metabolism of whatever microbes might be present, but it does not compensate for a pH that is too high. In other words, “stored in the fridge” is helpful for spoilage control, but it should not be used as a substitute for reaching the correct acidic conditions, especially for preventing botulinum toxin risk in acidified foods.
What signs should make me stop using vinegar or vinegar-based foods?
Yes for some spoilage organisms that tolerate acids more than typical foodborne pathogens. You may also see changes in flavor, haze, or sediment that reflect fermentation activity rather than pathogen growth. If you notice a musty, putrid, or unusually fermented odor, significant loss of sharp sourness, or active bubbling in a product that should be stable, discard it.
Can I use vinegar to sanitize food-contact surfaces?
For cleaning and disinfecting non-food surfaces, vinegar’s acidity can reduce some microbes, but it is not the same as using an EPA-registered disinfectant, and dilution weakens performance. If you are cleaning after potential food contamination, use a method designed for disinfection (clean first, then apply an appropriate product), and don’t rely on vinegar alone for guaranteed pathogen control.
Why does “mother of vinegar” happen more in some bottles than others?
Vinegar stored in a sealed container is less likely to develop acetic acid bacterial films because oxygen at the surface is limited. However, once oxygen is available and the liquid contains alcohol or partially fermented material, acetic acid bacteria can establish a biofilm even when pH is low. So storage choice affects what you might see, even if it does not usually indicate pathogen growth.
Can Bacteria Grow in Honey? Why It Usually Cannot
Learn why bacteria usually can’t grow in honey, what conditions allow survival or later growth, and safe handling tips.

